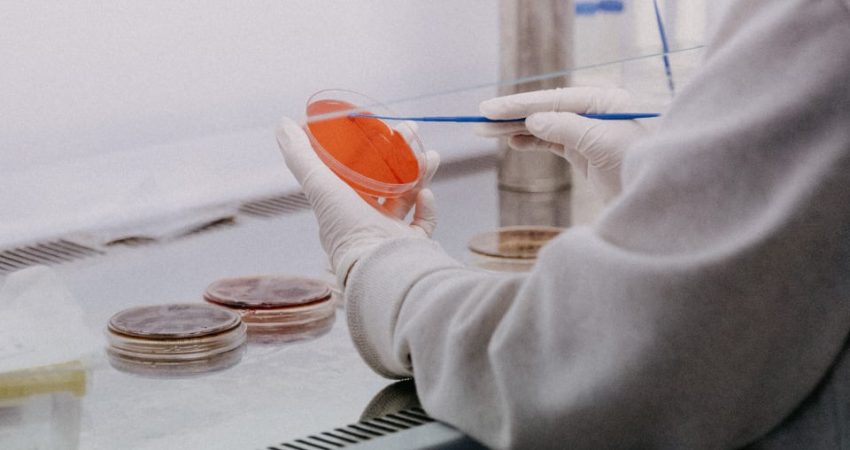

“Duket absurde ta thuash, por vetëm katër veta e dinë gjendjen time, përfshirë dhe mjekun që më ndjek gjithë kohës”, i tregon M.L Gazetasi.al.
I riu rreth 35 vjeç ka 3 vite e gjysmë që jeton me sëmundjen e HIV/AIDS, e për këtë gjendje ai e ka të vështirë të flasë.
“Prindërit e mi ngulmojë dita ditës që unë të martohem dhe të krijoj familje, por ata nuk e dinë asgjë për sëmundjen time. Atyre gjithmonë ju shmangem për pyetje të tilla apo kur përjetoj ndonjë simptomë. Madje edhe ilaçet i marr fshehurazi në dhomën time”, shton i riu.
Ai i tregoi Gazetasi.al se nuk do që t’i shqetësojë prindërit dhe t’i shpjegojë të gjithë mënyrën se si e mori sëmundjen.
“Fajin për këtë sëmundje e ka jeta e çrregullt që kam bërë. Të them të drejtën gjatë kohës që kam qenë në një stazh pune në shtetin italian, kam frekuentuar shumë njerëz të cilët sot e kësaj dite nuk i mbaj mend. Me saktësi nuk e di se nga kush e kam marrë sëmundjen por faji ka qenë i imi sepse nuk kam qenë i kujdesshëm. Eksperiencat e mia seksuale të pambrojtura më lanë me një barrë të madhe për të cilën është shumë e vështirë të flas”, shtoi ai.
Më tej i riu tregon se ka qenë mbartës i sëmundjes ndoshta shumë vite por testin e kishte kryer tre vjet më parë po në një klinikë në Itali. Ai shpjegon se lodhja e vazhdueshme dhe humbja peshës pa shpjegim e drejtuan tek testi i HIV/AIDS që fatkeqësisht i doli pozitiv.
M.L i tregon Gazetasi.al se kur e mori vesh “i ra qielli mbi kokë”.

Ai është me profesion laborant mjekësor dhe pavarësisht informimit që ka më shumë se sa situata ekonomike e rëndon ajo sociale. Sipas tij nuk është e thjeshtë. Siç thotë ai mbajtja sekret e kësaj gjendje ka bërë që të vazhdojë jetën pa e paragjykuar askush!
“Mua më tmerron ideja të distancohem për sëmundjen që kam dhe prandaj e kam mbajtur kaq të fshehtë. Para dy vitesh njoha një vajzë në punë. Shkonim shumë mirë bashkë por kur kuptova se po fillonim të kishim një pëlqim të ndërsjellët, u distancova. Do i beja keq…E di që personit të parë që ia kam besuar historinë time, i cili ka qenë shumë i rëndësishëm për mua sot e kësaj ditë nuk kam asnjë komunikim dhe asnjë kontakt vetëm se unë i thash që jam me HIV/AIDS. Duket e çuditshme por arsyeja ka qenë pikërisht për këtë!”, shton M.L.
35-vjeçari tregon se ka qenë në fazë jo të lehtë kur e ka identifikuar sëmundjen dhe i është dashur mbi një vit kohë që të mbajë nën kontroll virusin dhe simptomat të mos ishin të dukshme.
“Kur sëmurem familjarët thonë se kam imunitet të dobët por hallin e imunitetit tim pak e dinë”, tha ai.

Ai shpjegon për Gaztasi.al se sëmundja nuk e pengon në punë e tij, për të cilën tregohet tepër i kujdesshëm. Sipas mjekut të tij tashmë gjendja është e qëndrueshme për shkak të medikamenteve dhe të kujdesit që ai ka për veten por është i vetëdijshëm që e presin vështirësi fizike edhe më shumë.
“Kam në mendje gjithë kohës të kursej lekë, pasi mendoj që nëse bëhem keq ndonjë ditë të paktën prindërit e mi të kenë disa të ardhura nga unë. Vjet në prill u prekëm të gjithë si shtëpi nga Covid-19 dhe i thoja vetes që duhet të ngrihesha sepse prindërit e mi ishin të pamundur për të përballuar diçka të keqe nga unë. Kostoja e trajtimit ishte marramendëse… rreth 3 mijë euro!”, shton ai.
M.L i tha Gazetasi.al se përpos prindërve një tjetër peng të madh që ka është e nuk do mundet të krijojë familje. Ai shprehet se kur ka qenë i ri nuk e ka vlerësuar këtë fakt por tani e shikon si diçka për të cilën duhet të kishte luftuar shumë.
Dita Ndërkombëtare këtë vit e gjen Shqipërinë me më pak persona të infektuar se vitet e tjera, por një pjesë e madhe e zbulojnë sëmundjen në fazën e fundit. Të dhënat nga INSTAT tregojnë se në vendin tonë ka rreth 1400 të prekur nga ky infeksion. Tek të dhënat është konstatuar se gjatë vitit 2020 janë prekur 70 burra nga HIV/AIDS dhe 26 gra ku njëra prej tyre ishte dhe shtatzënë.
Ky virus i quajtur shkencërisht si “virusi i mungesës së imunitetit njerëzor”(HIV) sulmon sistemin imunitar të trupit. Kjo gjendje bën që të jetë e vështirë për trupin të luftojë çdo infeksion apo sëmundje tjetër të mundshme. Të dhënat shkencore prej kohësh kanë treguar se HIV është gjendja që çon në sindromin e mungesës së imunitetit të fituar (AIDS), e cila konsiderohet të jetë faza finale e HIV.
*Inicialet e personit janë ndryshuar për të ruajtur privatësinë e tij.
Copyright © Gazeta “Si”
Të gjitha të drejtat e këtij materiali janë pronë ekskluzive dhe e patjetërsueshme e Gazetës “Si”, sipas Ligjit Nr.35/2016 “Për të drejtat e autorit dhe të drejtat e tjera të lidhura me to”. Ndalohet kategorikisht kopjimi, publikimi, shpërndarja, tjetërsimi etj, pa autorizimin e Gazetës “Si”, në të kundërt çdo shkelës do mbajë përgjegjësi sipas nenit 179 të Ligjit 35/2016.
.png)

Lini një Përgjigje